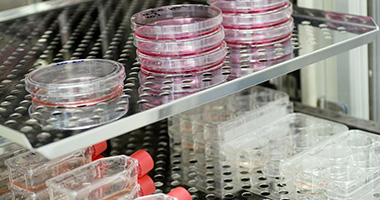

病毒包装一站式服务平台
慢病毒 (Lentivirus, LV) 属逆转录病毒科,是一种单链RNA病毒,是以人类免疫缺陷Ⅰ型病毒(HIV-1)为基础发展起来的基因治疗载体。慢病毒区别于一般的逆转录病毒,可以感染分裂或不分裂的多种类型的细胞,并能将外源基因整合到宿主基因组上实现长期稳定的表达。其作为体外和体内基因传递的有效工具,在科研和临床上得到广泛的应用。
华槃生物(HOPREN Bioscience) 采用第三代慢病毒包装系统,病毒滴度高、细胞毒性小、感染效率高,可提供过表达、干扰、基因敲除慢病毒及针对各种肿瘤抗原的CAR分子设计和CAR病毒包装服务。
较短的交付周期
最快2周交付慢病毒
高滴度
滴度最高可达1010TU/mL
优质的生物原料
无菌分装
无支原体或其他微生物污染
服务内容
基因合成、密码子优化(可选)
用户提供目的蛋白序列信息或质粒
载体构建
克隆至合适的表达载体
质粒测序
质粒制备
交付内容
测序报告(若客户要求)
慢病毒制备
慢病毒包装、生产、浓缩 QC分析
交付内容
浓缩慢病毒
质量检验报告(CoA)
慢病毒感染和稳定细胞株制备
(可选)
协商进行
客户提供已经验证的慢病毒质粒及相关信息(如名称、抗性、大小、序列或图谱、插入序列信息和测序结果等)
附加服务
为满足客户的特定需求,华槃生物还提供更加广泛的附加服务,如下所示:
稳定细胞株制备服务
体外细胞实验服务
动物实验服务
分子生物学实验服务
生物效应和功能评价服务
药物开发及药理学检测服务
服务流程

双方沟通确定实验需求及服务价格

签订技术服务合同并收取预付款

载体构建

慢病毒制备

慢病毒感染 (可选)
案例展示
常见问题解答
- 慢病毒感染的优势
慢病毒有广泛的宿主范围,能够有效地感染分裂和非分裂细胞,特别适合于一些难转染的细胞(如原代细胞、干细胞、不分化的细胞等)和对腺病毒感染具有较强免疫反应的细胞(如树突状细胞、单核细胞和间充质干细胞)等,能大大提高目的基因转导效率。
慢病毒能将外源基因有效地整合入宿主染色体上,介导目的基因稳定、长期的表达。可利用慢病毒建立稳定细胞株。
适用范围更广,不仅能用于体外实验,还能用于活体动物模型,比如动物成瘤实验、CAR实验等。
- 能否协助完成慢病毒感染的后续步骤?
可以。华槃生物不但提供高滴度慢病毒,还可以根据客户需求进行慢病毒的感染服务。如制备指定细胞的稳定细胞株、单克隆稳定细胞株,动物体内慢病毒感染,以及相关的分子生物学实验、体外细胞生物学实验、动物实验、淋巴细胞实验、各药理学实验等。
- 若想做病毒包装服务,需提供哪些信息?
客户提供序列进行基因合成(需额外收取费用)。
基因长度<1500bp,若滴度低于107IFU/ml免费重新包装一次。若两次均低于107IFU/ml,则不收取包装费。
1500bp≤基因长度<4000bp,若滴度低于107IFU/ml免费重新包装一次。若两次都低于107IFU/ml ,则只收取50% 的费用。
基因长度>3000bp,会明显影响慢病毒的滴度,需先进行评估。
立即咨询一站式病毒包装服务